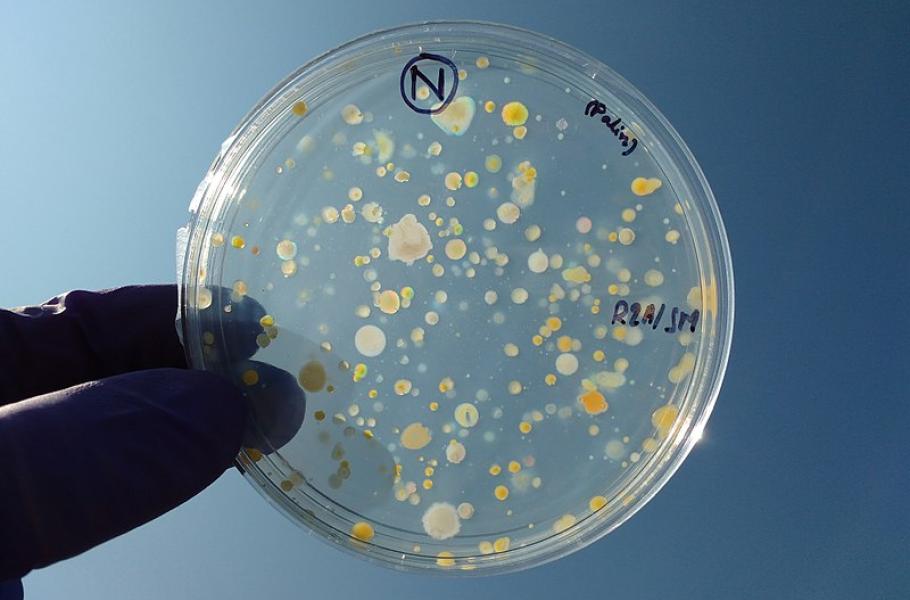

Nedávno objevený fabimycin ničí přes 300 různých rezistentních bakterií
Nedávno objevená látka fabimycin účinkuje proti bakteriím, které vyvolávají řadu obtížně léčitelných infekcí. Časem by se mohla stát novým antibiotikem…
(ilustrační foto: Wikimedia Commons, Satyamon1993, CC BY-SA 4.0)
Rezistence na antibiotika je dnes jednou z hlavních výzev pro vědce i zdravotnické organizace. Lidé jsou stále častěji ohrožováni rezistentními verzemi infekcí, které jsme už považovali za víceméně zdolané. Vědci a lékaři se proto snaží přijít s novými antibiotiky a léčebnými postupy, které by nám vrátily výhodu ve věčném souboji s patogeny.
Paul Hergenrother z Illinoiské univerzity v Urbaně-Champaigni vedl výzkumný tým, který narazil na látku zvanou fabimycin. Ukázalo se, že fabimycin je velice účinný proti gram-negativním bakteriím. Tyto baterie jsou zodpovědné za řadu velmi nebezpečných infekcí – v krvi, v plicích, ve vylučovací soustavě a na dalších místech lidského těla. Jejich léčba bývá svízelná, protože zmíněné bakterie jsou chráněné masivní buněčnou stěnou a výkonnými pumpami, které rychle zneškodní řadu antibiotik.
Slibný lék
Molekuly fabimycinu se vplíží do bakterie jako přízrak. Překonají buněčné stěny a vyhnou se pumpám. Velkou výhodou fabimycinu je, že není přehnaně nebezpečný pro užitečné bakterie v lidském těle, což bývá častým problémem nových léčebných postupů. Experimenty prokázaly, že fabimycin působí proti více než 300 různým typům rezistentních bakterií.
TIP: Nové antibiotikum zničí rezistentní bakterii jako otrávená šipka
Fabimycin vzbudil mezi odborníky velkou pozornost. Nestává se totiž každý den, že by došlo k objevu antibiotika účinného proti gram-negativním bakteriím. Fabimycin působí proti enzymu FabI, který má důležitou roli v biosyntéze mastných kyselin u bakterií. Badatelé si na fabimycinu pochvalují jeho vysokou účinnost a zároveň velmi nízký výskyt přirozené rezistence proti této látce u bakterií. Časem by se tak mohl stát novým antibiotikem, i když cesta k tomu je ještě pořádně dlouhá.



